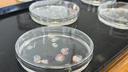
Otvorili limenku lososa staru 50 godina i šokirali se: 'Svi smo mislili da crvi znače da nešto nije u redu'

Večernji list
Večernji list
Otvorili limenku lososa staru 50 godina i šokirali se: 'Svi smo mislili da crvi znače da nešto nije u redu'
Tim predvođen Natalie Mastick i Chelsea Wood analizirao je 178 limenki lososa četiriju vrsta
Go to News Site
Večernji list
Večernji list
Tim predvođen Natalie Mastick i Chelsea Wood analizirao je 178 limenki lososa četiriju vrsta
Go to News Site